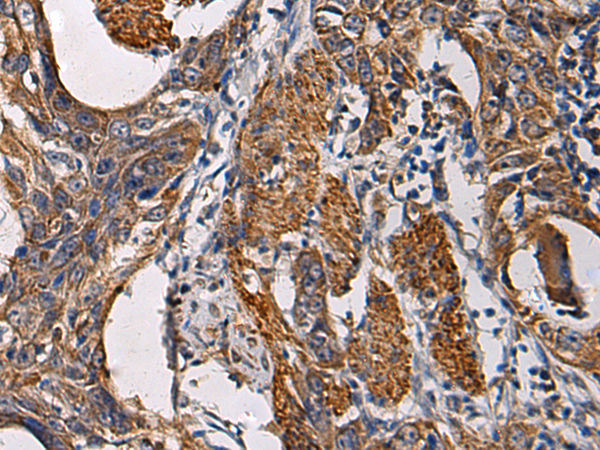

|
Background: |
The ADF (actin-depolymerizing factor)/cofilin family (see MIM 601442) is composed of stimulus-responsive mediators of actin dynamics. ADF/cofilin proteins are inactivated by kinases such as LIM domain kinase-1 (LIMK1; MIM 601329). The SSH family appears to play a role in actin dynamics by reactivating ADF/cofilin proteins in vivo (Niwa et al., 2002 [PubMed 11832213]). |
|
Applications: |
ELISA, IHC |
|
Name of antibody: |
SSH3 |
|
Immunogen: |
Fusion protein of human SSH3 |
|
Full name: |
slingshot protein phosphatase 3 |
|
Synonyms: |
SSH3L |
|
SwissProt: |
Q8TE77 |
|
ELISA Recommended dilution: |
5000-10000 |
|
IHC positive control: |
Human esophagus cancer and Human breast cancer |
|
IHC Recommend dilution: |
50-200 |

購物車
購物車 幫助
幫助
 021-54845833/15800441009
021-54845833/15800441009
